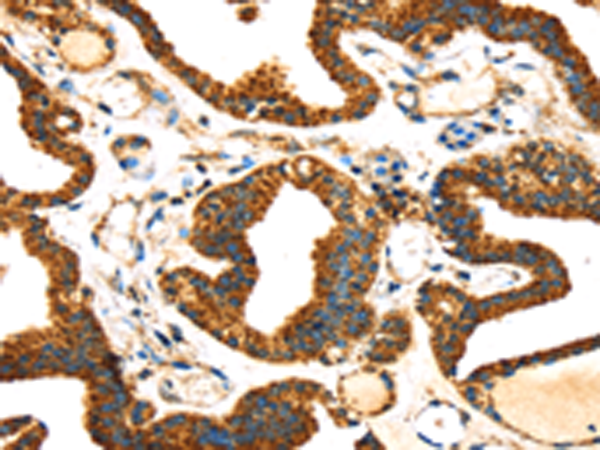

-
分类: 科研抗体货号: P08765别名: bA545I5.2应用: IHC反应种属: Human, Mouse
-
分类: 科研抗体货号: P08745别名: Cab45; SDF-4应用: IHC反应种属: Human, Mouse, Rat
-
分类: 科研抗体货号: P08755别名: AXAM2; SMT3IP2应用: IHC反应种属: Human, Mouse, Rat
-
分类: 科研抗体货号: P08776别名: ENT4; PMAT应用: WB,IHC反应种属: Human
-
分类: 科研抗体货号: P08762别名: SEST3应用: WB反应种属: Human, Mouse
-
分类: 科研抗体货号: P08754别名:应用: WB反应种属: Human, Mouse
-
分类: 科研抗体货号: P08775别名: VLCS; FATP2; VLACS; ACSVL1; FACVL1; hFACVL1; HsT17226应用: IHC反应种属: Human, Mouse, Rat
-
分类: 科研抗体货号: P08761别名: EPIPIN; SERPIN11应用: WB,IHC反应种属: Human, Mouse
-
分类: 科研抗体货号: P08753别名: DEN1; NEDP1; PRSC2应用: WB,IHC反应种属: Human, Mouse, Rat
-
分类: 科研抗体货号: P08773别名: SAMC应用: IHC反应种属: Human, Mouse

鄂公网安备42018502007531号
鄂公网安备42018502007531号

